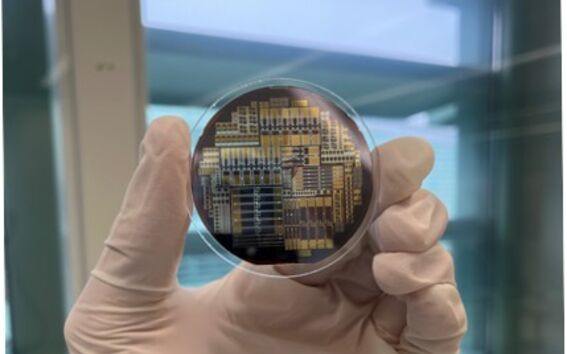
Experimental LEDs

Neurotieteen ja lääketieteellisen tekniikan laitos

Neurotieteen ja lääketieteellisen tekniikan laitos
Neurotieteen ja lääketieteellisen tekniikan laitoksella (NBE) tehdään systeemisen neurotieteen, multimodaalisen neurokuvantamisen, neurostimulaation, kokeellisen biofysiikan ja lääketieteellisen tekniikan maailmanluokan monitieteistä tutkimusta. Laitoksen tutkimuksen ja koulutuksen kuvauksen tasot ulottuvat molekyyli- ja solumittauksista ei-invasiiviseen aivokuvantamiseen ja käyttäytymisen mittauksiin.
Laitokselta valmistuneet työskentelevät yliopistoissa, teollisuudessa ja julkisella sektorilla ja edistävät tieteellisen tiedon hyödyntämistä yhteiskunnassamme. Tutkimustuloksemme ja innovaatiomme mahdollistavat myös uusien terveyttä ja hyvinvointia edistävien yritysten perustamisen.
Pikalinkit
Tutkimus
Monitieteisten tutkijoiden ja insinöörien uudet sukupolvet koulutetaan ottamalla heidät mukaan huipputieteeseen ja teknologiaan. Vahva panostus tutkimukseen näkyy myös laaja-alaisessa yhteistyössämme, henkilöstömme kansainvälisyydessä ja laajassa rahoituslähteiden kirjossa.
Aalto NeuroImaging (ANI) infrastruktuuri
Aalto NeuroImaging (ANI) -tutkimusinfrastruktuuriin kuuluu kolme aivokuvantamislaboratoriota: Advanced magnetic imaging (AMI) -keskus (toiminnallinen magneettikuvaus, fMRI), MEG Core...


Aalto Brain Centre (ABC)
ABC on Aalto-yliopiston neurotieteen ja -teknologian aloite. ABC on aihekohtainen keskus, jonka muodostavat Aalto-yliopiston perustieteiden korkeakoulun (Aalto SCI) usean eri laitoksen, mukaan lukien Neurotieteen ja lääketieteellisen tekniikan laitos, tutkimusryhmät. ABC lisää synergiaa ja yhteistyötä systeemisen neurotieteen, aivokuvantamisen ja neuroteknologian aloilla.

Biodesign Finland
Biodesign Finland on Aalto-yliopiston perustieteiden korkeakoulun strateginen aloite, jonka kotipaikkana toimii neurotieteen ja lääketieteellisen tekniikan laitos (NBE). Biodesign Finlandin ovat järjestäneet Aalto-yliopisto ja HUS yhteistyössä Metropolia-ammattikorkeakoulun kanssa.
Biodesign Finland on tarvelähtöinen lääketieteellisen tekniikan innovaatio- ja koulutusohjelma, joka tuottaa asiantuntijoita, ratkaisuja ja uutta liiketoimintaa terveydenhuollon alueelle.
Biodesignin tavoitteena on tarjota paras lähtökohta uuden terveysteknologian luomiselle potilaan parhaaksi kansainvälisesti.
Uutiset

EU:n kilpailtu miljoonarahoitus kolmelle Aalto-yliopiston tutkijalle
Tutkimukset pureutuvat atomintarkkaan materiaalitekniikkaan, ledeihin perustuvaan lämpöhallintaan ja kvanttimenetelmiin hajautetuissa verkoissa.
Aalto-yliopisto on mukana neljässä tutkimushankkeessa Business Finlandin merkittävässä rahoitushaussa
Näytönpaikka-rahoituksen saaneissa hankkeissa kehitetään valtakunnallinen terveydenhuollon tekoälymalli, teknologiaa kvanttitietokoneiden skaalaamiseen, uuden tarkkuustason kuvantamista ja kvanttilaskentaa monimutkaisten biologisten ongelmien ratkaisuun.
Avoimen julkaisemisen artikkelikiintiöitä loppumassa syksyn 2026 aikana
Elsevierin, Wileyn, Taylor & Francisin ja Emeraldin artikkelikiintiöiden arvioidaan loppuvan syksyn 2026 aikana.
Elsevierin Read & Publish –sopimuksen tulevaisuus: tietoa tutkijoille
Kansallinen sopimus Elsevierin kanssa on voimassa vuoden 2026 loppuun asti.Tapahtumat

Tutkimusrahoituksen seminaarisarja, osa 1/2: merkittävimmät kansalliset rahoitusmahdollisuudet tutkimushankkeille, 15.9.2026
Aalto-yliopiston tutkimuspalveluiden järjestämässä seminaarissa esitellään merkittävimmät kansalliset rahoitusinstrumentit, kuten Suomen Akatemia, Business Finland ja suurimmat säätiöt.
Tutkimusrahoituksen seminaarisarja, osa 2/2: hakemusten kirjoittaminen, painopisteenä Suomen Akatemian rahoitus, 29.9.2026
Aalto-yliopiston tutkimuspalvelut järjestää seminaarin rahoitushakemusten kirjoittamisesta Suomen Akatemian talvihakuun 2027.Yhteystiedot
Neurotieteen ja lääketieteellisen tekniikan laitos
Aalto-yliopisto, Perustieteiden korkeakoulu
PL 12200
00076 AALTO
Health Technology House
Rakentajanaukio 2 C
02150 Espoo
Magneettitalo
Otakaari 5 I
02150 Espoo
MEG Core -tutkimusinfrastruktuuri sijaitsee Nanotalossa (Puumiehenkuja 2). Marsiossa (Otakaari 2) on ABL:n mittaushuoneita.
Engineered Nanosystems -tutkimusryhmän toimistoja ja laboratorioita on Tietotie 1A:ssa ja Micronovassa (Tietotie 3) .